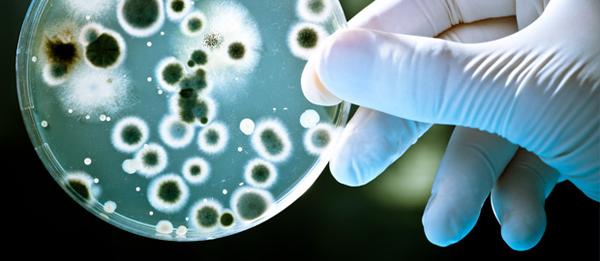
Người Đức và những sáng chế nổi tiếng thế giới khiến nhiều người bất ngờ - 2

Nước Đức không chỉ nổi tiếng với bia, xúc xích hay ô-tô mà còn là nơi sản sinh ra những phát minh hữu ích tuyệt vời.
Khi nhắc tới Đức, người ta thường nghĩ ngay tới đặc sản bia và các lễ hội bia tầm cỡ thế giới được tổ chức hàng năm.
Nhưng lật giở lại từng trang lịch sử khoa học - đời sống của nhân loại mới thấy, người Đức thực sự đáng được tôn vinh với những phát minh, sáng chế mang tính thiết thực cho cuộc sống.
Johannes Gutenberg, Ferdinand Porsche hay Karl Benz là những kỹ sư, nhà phát minh, nhà khoa học nổi tiếng người Đức.
Chính họ là những người sáng tạo nên những đồ gia dụng hữu ích mà bạn sẽ thấy bất ngờ ngay sau đây.

Thuốc giảm đau:
Mỗi lần cảm thấy nhức đầu hay bị đau mỏi cơ thể, bạn dùng những viên nén giảm đau Aspirin thì hãy nhớ thầm cảm ơn nhà hóa học người Đức, Felix Hoffmann.
 |
Ôtô: Kỹ sư người Đức Karl Benz là người đầu tiên tạo ra cơ sở cho loại phương tiện giao thông phổ biến nhất trên thế giới hiện nay. Vào năm 1885, Benz đã phát triển chiếc ôtô đầu tiên chạy bằng xăng.
Hiện hãng ô tô Mercedes Benz của nước này cũng là một trong những thương hiệu xe hơi nổi tiếng và đắt giá nhất trên thế giới.
|
Vi khuẩn học:
Năm 1870, nhà khoa học người Đức Robert Koch đã phát hiện ra sự tồn tại của vi khuẩn sau khi gia súc trên khắp châu Âu bị ảnh hưởng bởi một căn bệnh bí ẩn. Đó là tiền đề cho sự ra đời của Bacteriology - ngành Vi khuẩn học đang rất phát triển. Nếu không có sự khám phá của Koch thì rất có thể nhiều thế kỷ sau đó con người vẫn phải sống trong sợ hãi bệnh tật.
 |
Đàn Accordion: Năm 1822, nhà sáng chế người Đức Christian Friedrich Buschmann đã tạo ra mô hình cơ bản đầu tiên của loại đàn accordion. Cho đến nay, thứ nhạc cụ này vẫn đang làm đắm say biết bao trái tim người yêu âm nhạc dân gian Đức.
 |
Kẹo dẻo: Người Đức mến mộ gấu và hình tượng của loài động vật này xuất hiện khá nhiều trong đời sống của họ. Năm 1920, doanh nhân người Đức Hans Riegel đã làm ra những chiếc kẹo dẻo hình gấu đầy ngọt ngào và dễ gặm nhấm. Công ty kẹo của Riegel mang tên Haribo đến nay vẫn tiếp tục sản xuất những chiếc kẹo “chip-chip” hình con gấu.
 |
Mắt kính áp tròng: Tiến sĩ người Đức, Adolf Gaston Eugen Fick, chính là người đã xây dựng ý tưởng và trang bị mắt kinh áp tròng đầu tiên cho con người vào năm 1887. Vị bác sĩ nhãn khoa này trước đó đã thử nghiệm kính áp tròng trên thỏ, trước khi lắp chúng vào mắt người.
 |
Quần jeans: Levi Strauss, một thương gia người Mỹ gốc Đức và Jacob David là những người đầu tiên được cấp bằng sáng chế vào năm 1873, cho mẫu quần được gọi là “jean”, có màu xanh và ban đầu được thiết kế cho những cao bồi và thợ mỏ.
 |
Lớp mẫu giáo:
Trình độ học sơ khai của bất kỳ đứa trẻ nào trên thế giới, hóa ra lại là một sáng kiến của các nhà giáo dục Đức.
Theo tiếng Đức, từ “mẫu giáo” mang nghĩa là “khu vườn dành cho trẻ em”. Cơ sở mẫu giáo đầu tiên trên thế giới được đưa vào hoạt động từ năm 1837, dựa theo ý tưởng và tâm huyết của giáo sư người Đức Friedrich Frobel. Frobel cho rằng, tâm trí của trẻ nhỏ phải được nuôi dưỡng như những cái cây trong vườn.
 |
Xe đạ: Năm 1817, Baron Karl von Drais đã phát minh ra chiếc “máy chạy” mang tên Laufmaschine-German, cỗ máy gồm hai bánh có thể di chuyển được chế tạo từ gỗ. Sau này, người Pháp sáng tạo thêm bàn đạp và xe đạp cho tới ngày nay đã càng được hoàn thiện.
 |
Tia X: Nhà vật lý người Đức, Wilhelm Conrad Rontgen vào năm 1895 đã phát hiện ra tia X và tìm cách sử dụng chúng vào những ứng dụng y học như ngày nay.
 |
Máy phát nhạc: Nhà phát minh người Đức, Emile Berliner, là người tạo nên “máy hát” mang tên gramophone, đó cũng chính là máy nghe nhạc đầu tiên trên thế giới. Những chiếc “máy hát” này phát nhạc bằng các bản ghi trên đĩa có rãnh được khuếch đại bằng một đầu kim.
 |
Mayonnaise: Khi đầu bếp người Pháp mang tên Duke de Richelieu lần đầu tiên tạo ra majonnaise vào năm 1756, thì thực tế những nguyên liệu và cách thức chế biến ra mayonnaise đã được một người Đức nhập cư mang tên Richard Hellmann làm ra vào năm 1905. Sau này thương hiệu mayonnaise Hellmann’s cũng nổi tiến khắp thế giới.
Nguồn IONE.








